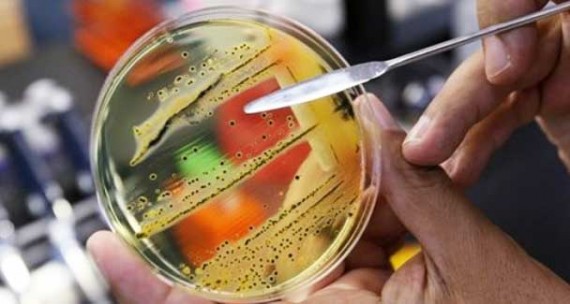

Antibiotics Era Ending?
Mutated bacteria spreading in India could mark the end of effective antibiotic drugs. The medical repercussions would be enormous.
A new study reveals that a mutated bacteria spreading in India could mark the end of effective antibiotic drugs.
The era of antibiotics is coming to a close. In just a couple of generations, what once appeared to be miracle medicines have been beaten into ineffectiveness by the bacteria they were designed to knock out. Once, scientists hailed the end of infectious diseases. Now, the post-antibiotic apocalypse is within sight.
Hyperbole? Unfortunately not. The highly serious journal Lancet Infectious Diseases yesterday posed the question itself over a paper revealing the rapid spread of multi-drug-resistant bacteria. “Is this the end of antibiotics?” it asked.
Doctors and scientists have not been complacent, but the paper by Professor Tim Walsh and colleagues takes the anxiety to a new level. Last September, Walsh published details of a gene he had discovered, called NDM 1, which passes easily between types of bacteria called enterobacteriaceae such as E. coli and Klebsiella pneumoniae and makes them resistant to almost all of the powerful, last-line group of antibiotics called carbapenems. Yesterday’s paper revealed that NDM 1 is widespread in India and has arrived here as a result of global travel and medical tourism for, among other things, transplants, pregnancy care and cosmetic surgery.
“In many ways, this is it,” Walsh tells me. “This is potentially the end. There are no antibiotics in the pipeline that have activity against NDM 1-producing enterobacteriaceae. We have a bleak window of maybe 10 years, where we are going to have to use the antibiotics we have very wisely, but also grapple with the reality that we have nothing to treat these infections with.”
This would have very serious consequences:
• Transplant surgery becomes virtually impossible. Organ recipients have to take immune-suppressing drugs for life to stop rejection of a new heart or kidney. Their immune systems cannot fight off life-threatening infections without antibiotics.
• Removing a burst appendix becomes a dangerous operation once again. Patients are routinely given antibiotics after surgery to prevent the wound becoming infected by bacteria. If bacteria get into the bloodstream, they can cause life-threatening septicaemia.
• Pneumonia becomes once more “the old man’s friend”. Antibiotics have stopped it being the mass-killer it once was, particularly among the old and frail, who would lapse into unconsciousness and often slip away in their sleep. Other diseases of old age, such as cancer, have taken over.
• Gonorrhea becomes hard to treat. Resistant strains are already on the rise. Without treatment, the sexually transmitted disease causes pelvic inflammatory disease, infertility and ectopic pregnancies.
• Tuberculosis becomes incurable – first we had TB, then multi-drug-resistant TB (MDR-TB) and now there is XDR-TB (extremely drug resistant TB). TB requires very long courses (six months or more) of antibiotics. The very human tendency to stop taking or forget to take the drugs has contributed to the spread of resistance.
We’ve been hearing warnings about this for a while now. But, surely, brilliant scientists will just invent new antibiotics?
Since the 1990s, when pharma found itself twisting and turning down blind alleys, it has not shown a great deal of enthusiasm for difficult antibiotic research. And besides, because, unlike with heart medicines, people take the drugs for a week rather than life, and because resistance means the drugs become useless after a while, there is just not much money in it.
Well, fine. But most of this sort of research is funded by government grants. Surely, we can just shift more money in that direction if the market can’t do it?
Ten years ago, the so-called superbug MRSA caused front-page panic. Hospital patients were picking up Staphylococcus aureus infections that were resistant to the hitherto powerful antibiotic methicillin. All-out war, led by the [British] government’s former chief medical officer Sir Liam Donaldson, against MRSA and also C. diff (Clostridium difficile) has reduced the threat of what are known as Gram-positive bacteria. Hospital hygiene has been massively stepped up and, in response in part to public anxiety, pharmaceutical companies have put money into finding new antibiotics for those infections.
But it’s like putting a finger in a hole in the dam, only to find the water surges out somewhere else. Bacteria are great survivors. The biggest threat now, experts believe, is from multi-drug-resistant Gram-negative bacteria, such as NDM 1-producing enterobacteriaceae and an enzyme called KPC which has spread in the US (and in Israel and Greece) which also gives bacteria resistance to the carbapenems, the most powerful group of antibiotics we (once) had.
“The emergence of antibiotic resistance is the most eloquent example of Darwin’s principle of evolution that there ever was,” says [Dr. David] Livermore [director of the antibiotic resistance monitoring and reference laboratory of the Health Protection Agency]. “It is a war of attrition. It is naive to think we can win.”
While I’ll defer to Dr. Livermore’s infinitely greater expertise on the matter, I still have some faith that medical science will figure this out.
Actually, all this means is that we will have to play catchup on bacteriophage technology.
It’s possible that it’s the end. Or a brink of reduced options.
I think I told this story before. I’d crashed mountain biking and split my finger. I went to Kaiser for stitches. I noticed that the tech put on a pair of fresh gloves and then really carefully opened a suture kit on a table. He did it by carefully touching only edges of the kit with his fresh gloves. Once it was open, he carefully removed his first gloves and then put on a set from within the kit. He proceeded to stitch up my finger using only sterile contents of the kit.
It was striking, because here I was, covered heat to toe with actual dirt. He had sprayed and swabbed my finger a bit, but it was really obvious that he considered his examination room to be a greater threat.
Generally, when I visit Kaiser now, I try not to touch things.
“It was striking, because here I was, covered heat to toe with actual dirt. He had sprayed and swabbed my finger a bit, but it was really obvious that he considered his examination room to be a greater threat.”
Nosocomial infections, specifically, MRSA, are a big, big problem.
I work in the Medical Device industry, but of course what goes on in Pharma is closely related and I follow it. It is therefore a frustration when I hear talk about how health care reform will stifle the release of new drugs, because such talk is based on such a fundamental misunderstanding of how our system works.
Basically, university researchers work on basic drug research, primarily with government money. Of the promising drugs found, Pharma selects a few and then spends the hundreds of millions necessary to perfect the drugs and bring them through trial to market. But how does Pharma select which drugs to pursue? They use a standard business tool such as NPV to evaluate which drugs will create maximum profit over their IP protected lifetime. There is nothing in there about need, or benefit to patients, or affect on our society as a whole.
This is why there are so many anti-cholesterol drugs, or non-steroidal pain relievers (expensive aspirin) and so few new drugs to cure diseases, or vaccines to prevent them. Because once you’re on an anti-cholesterol drug, you’re on it for life. Steady income. Once you take a vaccine, you’re good with it. There’s another side effect here. If you have high cholesterol, your media horizon is saturated with warnings about it. There are sales reps in the doctors office constantly talking about the importance of getting it down. This works against the simple but highly effective treatments. For example, if a patient exhibiting chest pains is given an aspirin (powerful but inexpensive blood thinner) immediately, they has a dramatically better prognosis than those that are simply hooked up to every gadget known to man. For crying out loud, even though every cardiac care professional knows this, a significant percentage of US hospitals still don’t do it as a matter of routine. There’s no aspirin sales reps pushing it.
This is the system we have, a highly capitalistic one. I’m not saying it is awful, but it is certainly not set up to find cures for diseases. Thinking it does is naive. In fact, the next time you hear of a dramatic new medicine that actually cures something, read the article carefully and I’ll bet you’ll find it is an existing medication being used off label for something other than it’s intended use.
Doctors and scientists have not been complacent
Maybe some haven’t, but others prescribe antibiotics on a whim. The sniffles? Here’s your prescription. My mother-in-law seems to take antibiotics for half the winter and spring for nothing worse than allergy symptoms, with her doctor husband not saying a word.
Sorry, it’s people like that whose fault it is.
It is interesting how industry’s choice in drugs, the desire to find prescriptions-for-life, as MarkedMan says, is so little discussed.
There are several points that need to be made here. First, the Indian government denies this report vehemently, characterizing it as propaganda from the U. S. medical industry in response to medical tourism. I have no idea of where the truth lies in this matter.
Second, antibiotics are widely available over the counter both in India (where many antibiotics are packaged) and China (where many antibiotics are manufactured). Enforcement of what laws there are is lax and, worse, adulterated or diluted antibiotics are common. The combination of wide availability, lack of understanding of proper use, lax enforcement, and likely dilution creates an environment that’s nearly perfect for the development of antibiotic-resistant bacteria.
Third, the situation is somewhat worse than James intimates. Not only are pharmaceutical companies less interested in producing new antibiotics, they’re getting harder to create. We’ve picked the low-hanging fruit. It’s uphill from now on.
Fourth, travel restrictions would appear to be the elephant in the room. We’ve had them before and it may be necessary to introduce them again.
Are seriously infectious organisms (and to be proper, viruses) handled at university level?
Ebola? HIV? That’s a real question.
This sort of thing is frightening and expensive. My brother recovered from the stage IV Hodgkins of the bone marrow that was misdiagnosed and bandied about for nigh on two years, but is now in the hospital for about a month today for vertebral osteomyelitis which can only be traced to a bedsore from that bout two years ago.
Since the baby boomers have pushed so many other envelopes, maybe they will here, too.
Sorry, not reading well, Marked Man.
And not to say that he has some rare disease that cannot be treated. His is a normal staph that is responding to vancomycin.
“The emergence of antibiotic resistance is the most eloquent example of Darwin’s principle of evolution that there ever was,… It is a war of attrition. It is naive to think we can win.” Dr David Livermore
What he is saying James, is that the “war” will never be over. No matter what new anti-biotics we come up with, bacterias develope resistance to them…. ad infinitim.
My youngest son almost lost his leg to an MRSA. One of the scariest things I have ever been thru.
Janis, my son responded to the vancomycin as well. But there was some question as to whether it would work at first, and if it did, would it continue to, and also would there be damage to my son’s kidneys afterward.
Hopefully your brother will come out as well as my son did.
“What he is saying James, is that the “war” will never be over. No matter what new anti-biotics we come up with, bacterias develope resistance to them…. ad infinitim.”
Perhaps that’s a bit too pessimistic. Species do become so good at competing that they dominate their niche for millions, even hundreds of millions of years (horseshoe crab, sharks, etc.) It’s conceivable we could use our intelligence to come up with something that keeps a given disease from even getting a toe hold on the evolutionary ladder. Or, and this may be more likely, we cause it to adapt so many times that its virulence or effect is greatly reduced. After all, if a bacteria changes its “strategy” for infection, it is unlikely that the change strengthens it overall, and a real possibility that it weakens it a bit. Enough such adaptations and we might not need to worry about it. After all, being infected with a bacteria alone is not a problem, we have thousands of species in us right now. It’s being infected with a virulent, damaging species that is the problem.
How did your son come by osteomyelitis, Tom P? A break?
<blockquote>First, the Indian government denies this report vehemently, characterizing it as propaganda from the U. S. medical industry in response to medical tourism. </blockquote>
That’s definitely nonsense on the part of the Indian government. For one thing, it’s not the Americans promoting this – the study was based in India and the UK, and the researchers found strains of it both in South Asia as well as among South Asian expatriates in the UK.
For another, as <a href=”http://www.superbugtheblog.com/2010/08/ndm-1-novel-global-complex-and-serious.html”>this</a> points out, Indian researchers have been warning of this for years.
<blockquote>The combination of wide availability, lack of understanding of proper use, lax enforcement, and likely dilution creates an environment that’s nearly perfect for the development of antibiotic-resistant bacteria.</blockquote>
I agree. That’s one of the things that makes the whole situation so dangerous, since in combination with the above factors, any infection would spread extremely rapidly among the over-crowded cities in India.
If it’s any consolation, we’re not quite on the brink yet. Only one of the NDM-1 strains was completely resistant to all known antibiotics, with the rest being treatable by a combination of them.
<blockquote>Fourth, travel restrictions would appear to be the elephant in the room. We’ve had them before and it may be necessary to introduce them again.</blockquote>
Didn’t they used to do that 100 years ago for immigrants coming through New York? If you showed any trace of disease, it’s off to quarantine with you for several weeks.
Crap, the whole thing got screwed up. Here it is corrected:
That’s definitely nonsense on the part of the Indian government. For one thing, it’s not the Americans promoting this – the study was based in India and the UK, and the researchers found strains of it both in South Asia as well as among South Asian expatriates in the UK.
For another, Indian researchers have been warning of this for years.
I agree. That’s one of the things that makes the whole situation so dangerous, since in combination with the above factors, any infection would spread extremely rapidly among the over-crowded cities in India.
If it’s any consolation, we’re not quite on the brink yet. Only one of the NDM-1 strains was completely resistant to all known antibiotics, with the rest being treatable by a combination of them.
Didn’t they used to do that 100 years ago for immigrants coming through New York? If you showed any trace of disease, it’s off to quarantine with you for several weeks.
Ye gawd. i didn’t think I’d go down this road. But there is some sense in it.
“How did your son come by osteomyelitis, Tom P? A break?”
They never could figure it out Janis. (His case was supposedly written up in a couple of med journals) No broken leg, no contact with anyone recently released from the hospital, no public swimming pools, no etc etc. None of the at risk catagories seemed to apply to him.
The best they could come up with was he had exzema (staph LOVES exzema) and he picked up the MRSA in a feak occurence. It migrated to his femur because the bone was “stressed” at some point in time (he was a gymnast)(not bad either) the actual mechanism????
This was back in ’98-99, the “early days” of MRSA when they still weren’t sure of what they had, how it worked, or how to deal with it. I am sure now an Infectious Disease specialist could explain it all
I’m curious as to why people are just now worried about this. I remember reading decades ago a study showing that the over prescribing of antibiotics would have this result…